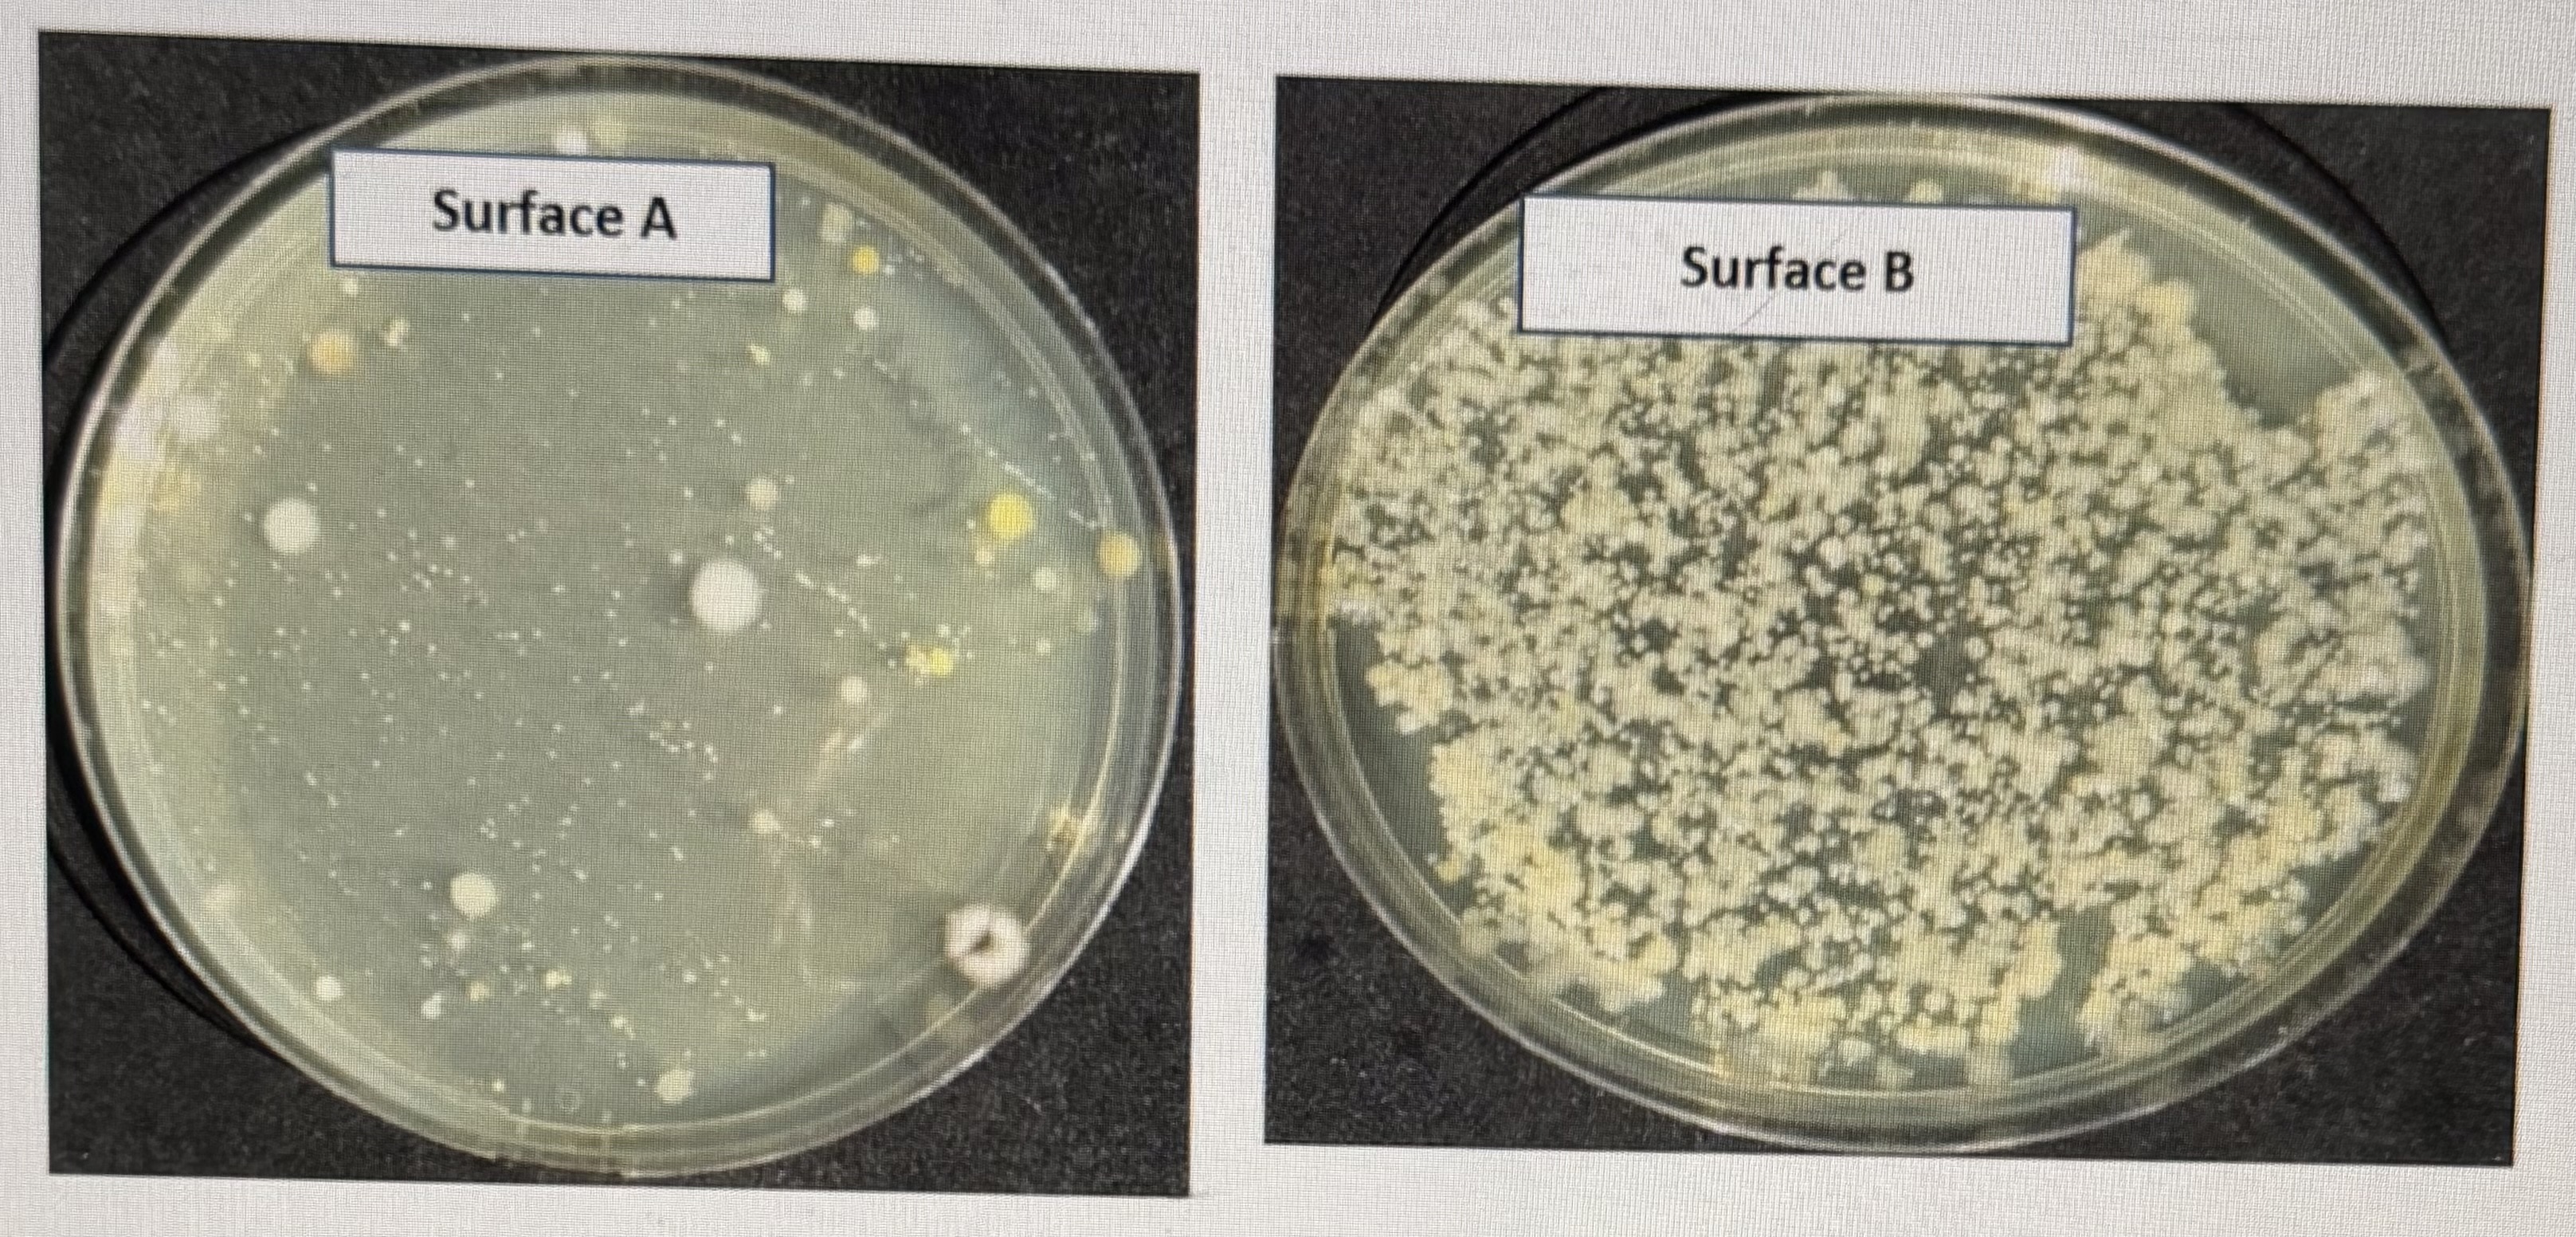
<p>Surface A supports the growth of bacteria</p><p>Surface A shows more growth of organisms than B</p><p>Surface B shows more growth of organisms than A</p><p>Surface A supports the growth of viruses</p>
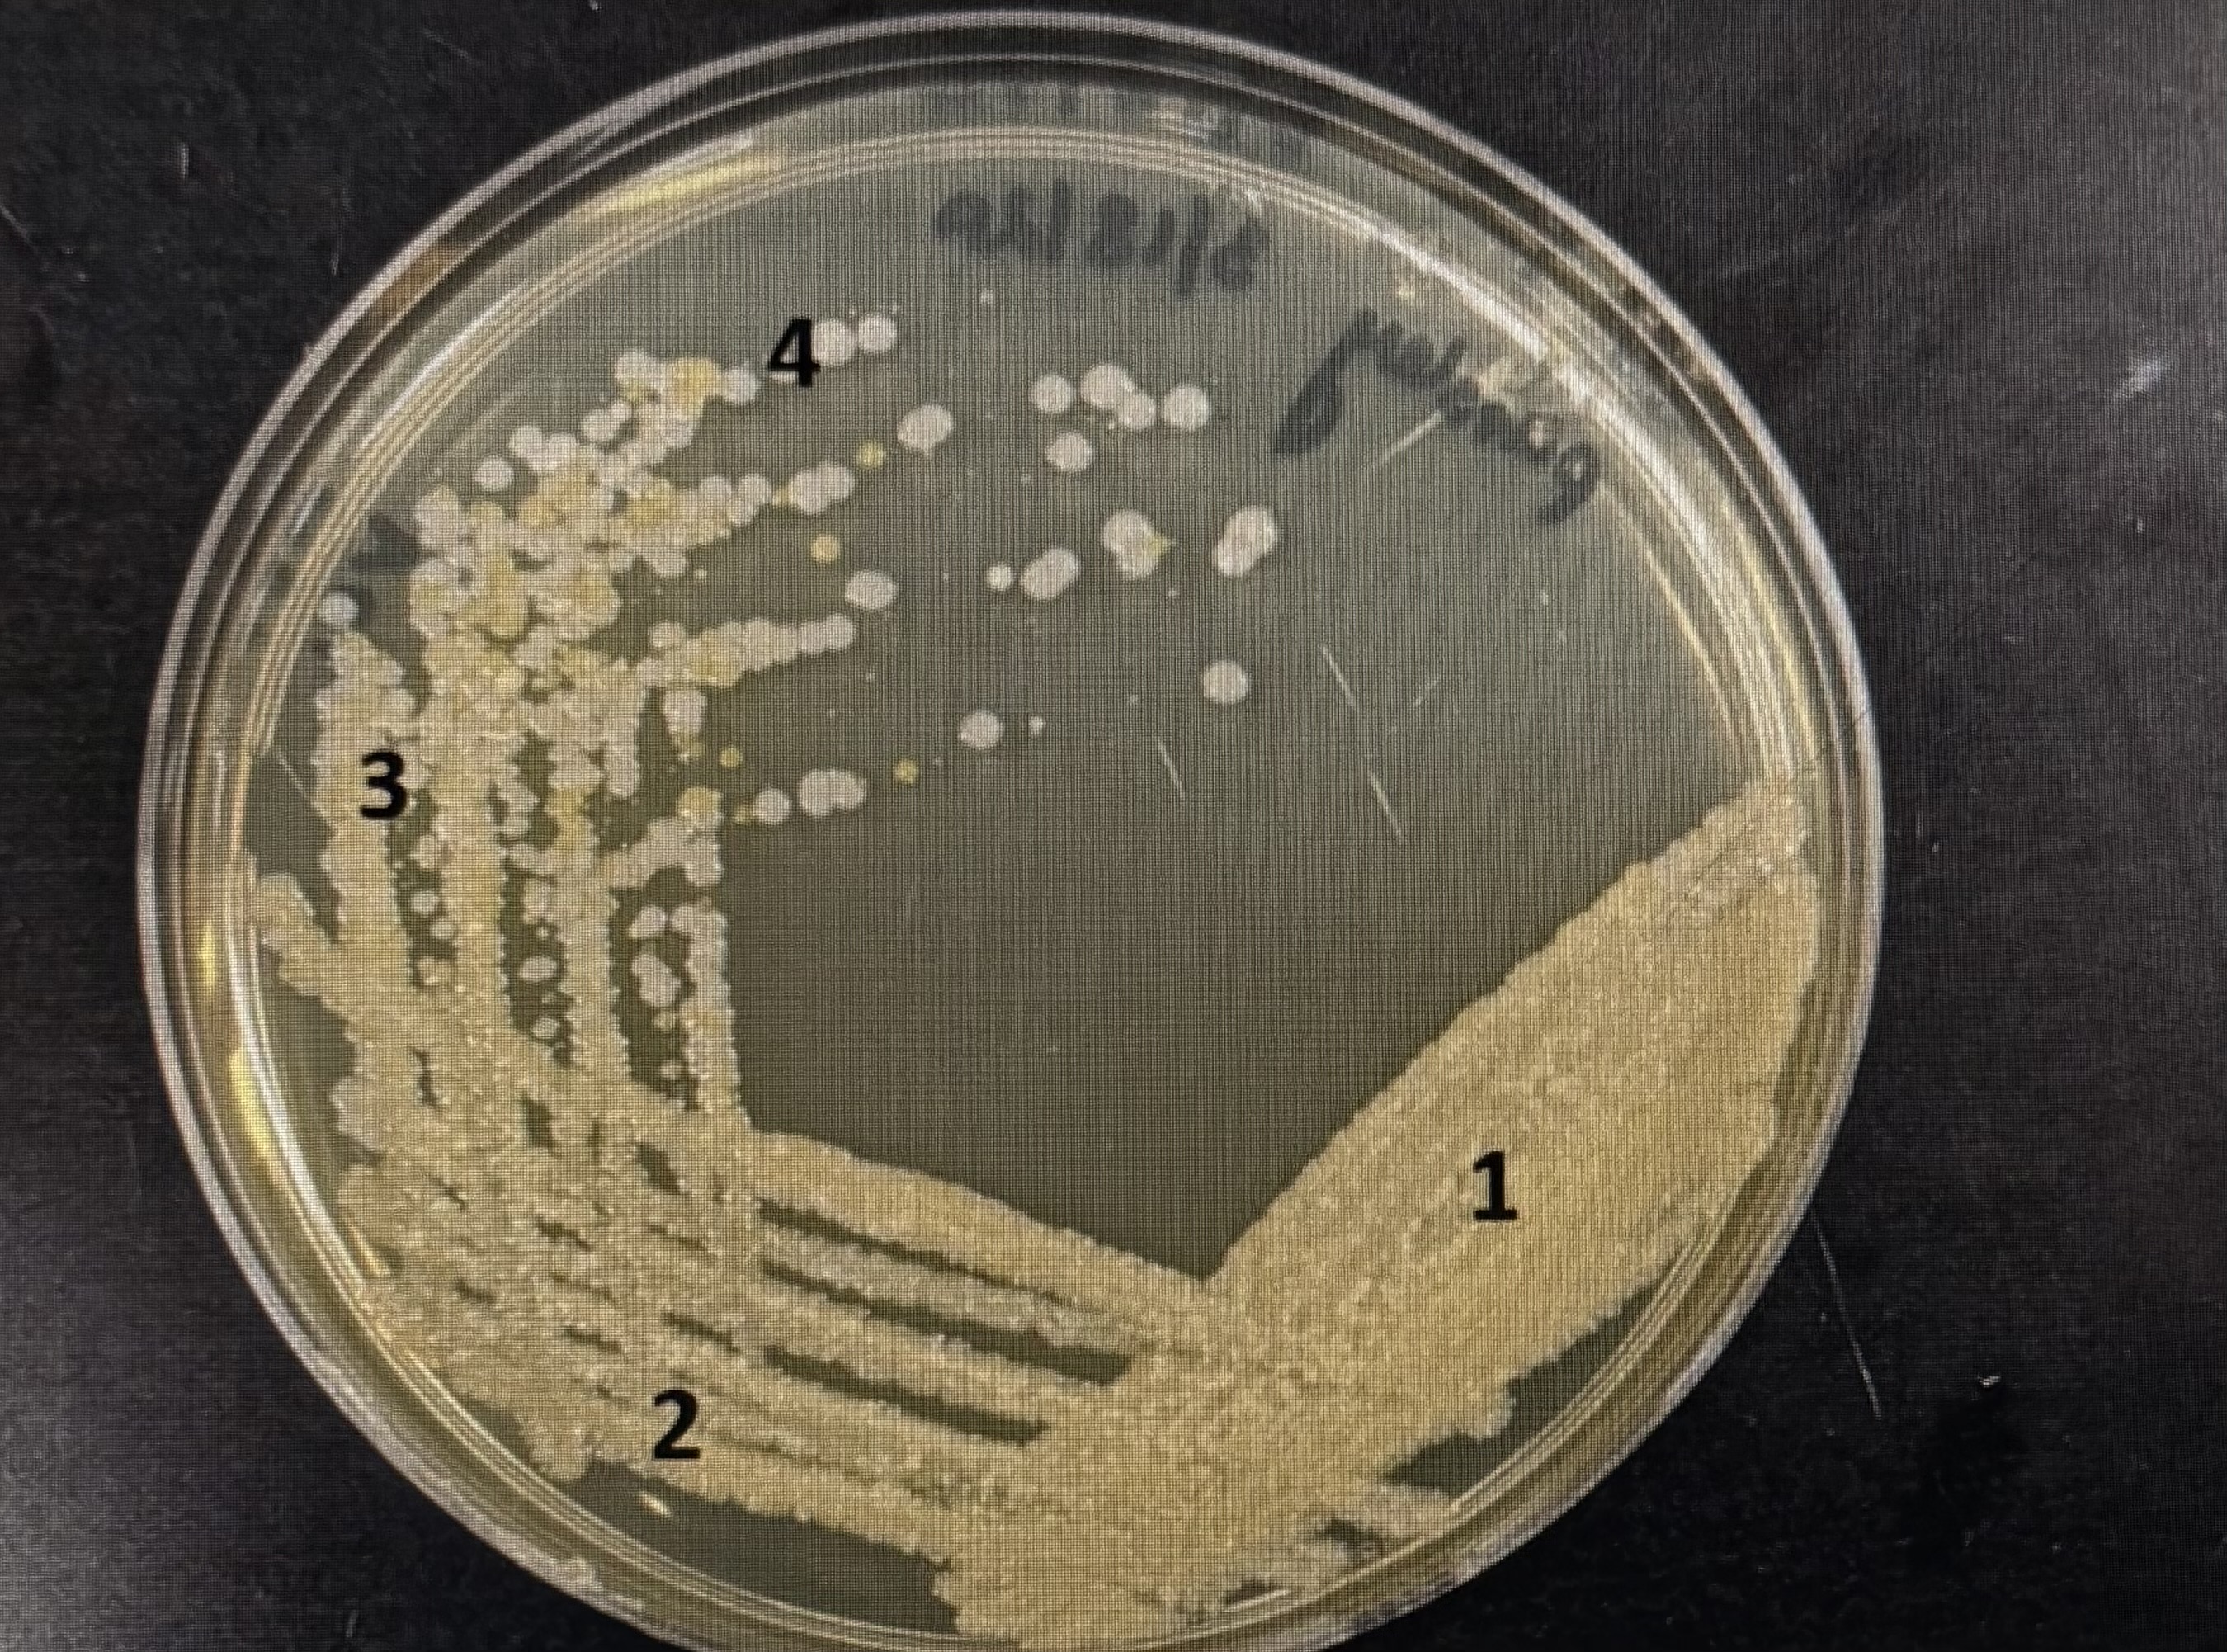
<p>The following plate was streaked in what order starting from first to last?</p><p>1,2,3,4</p><p>4,3,2,1</p><p>2,1,3,4</p><p>4,1,2,3</p>
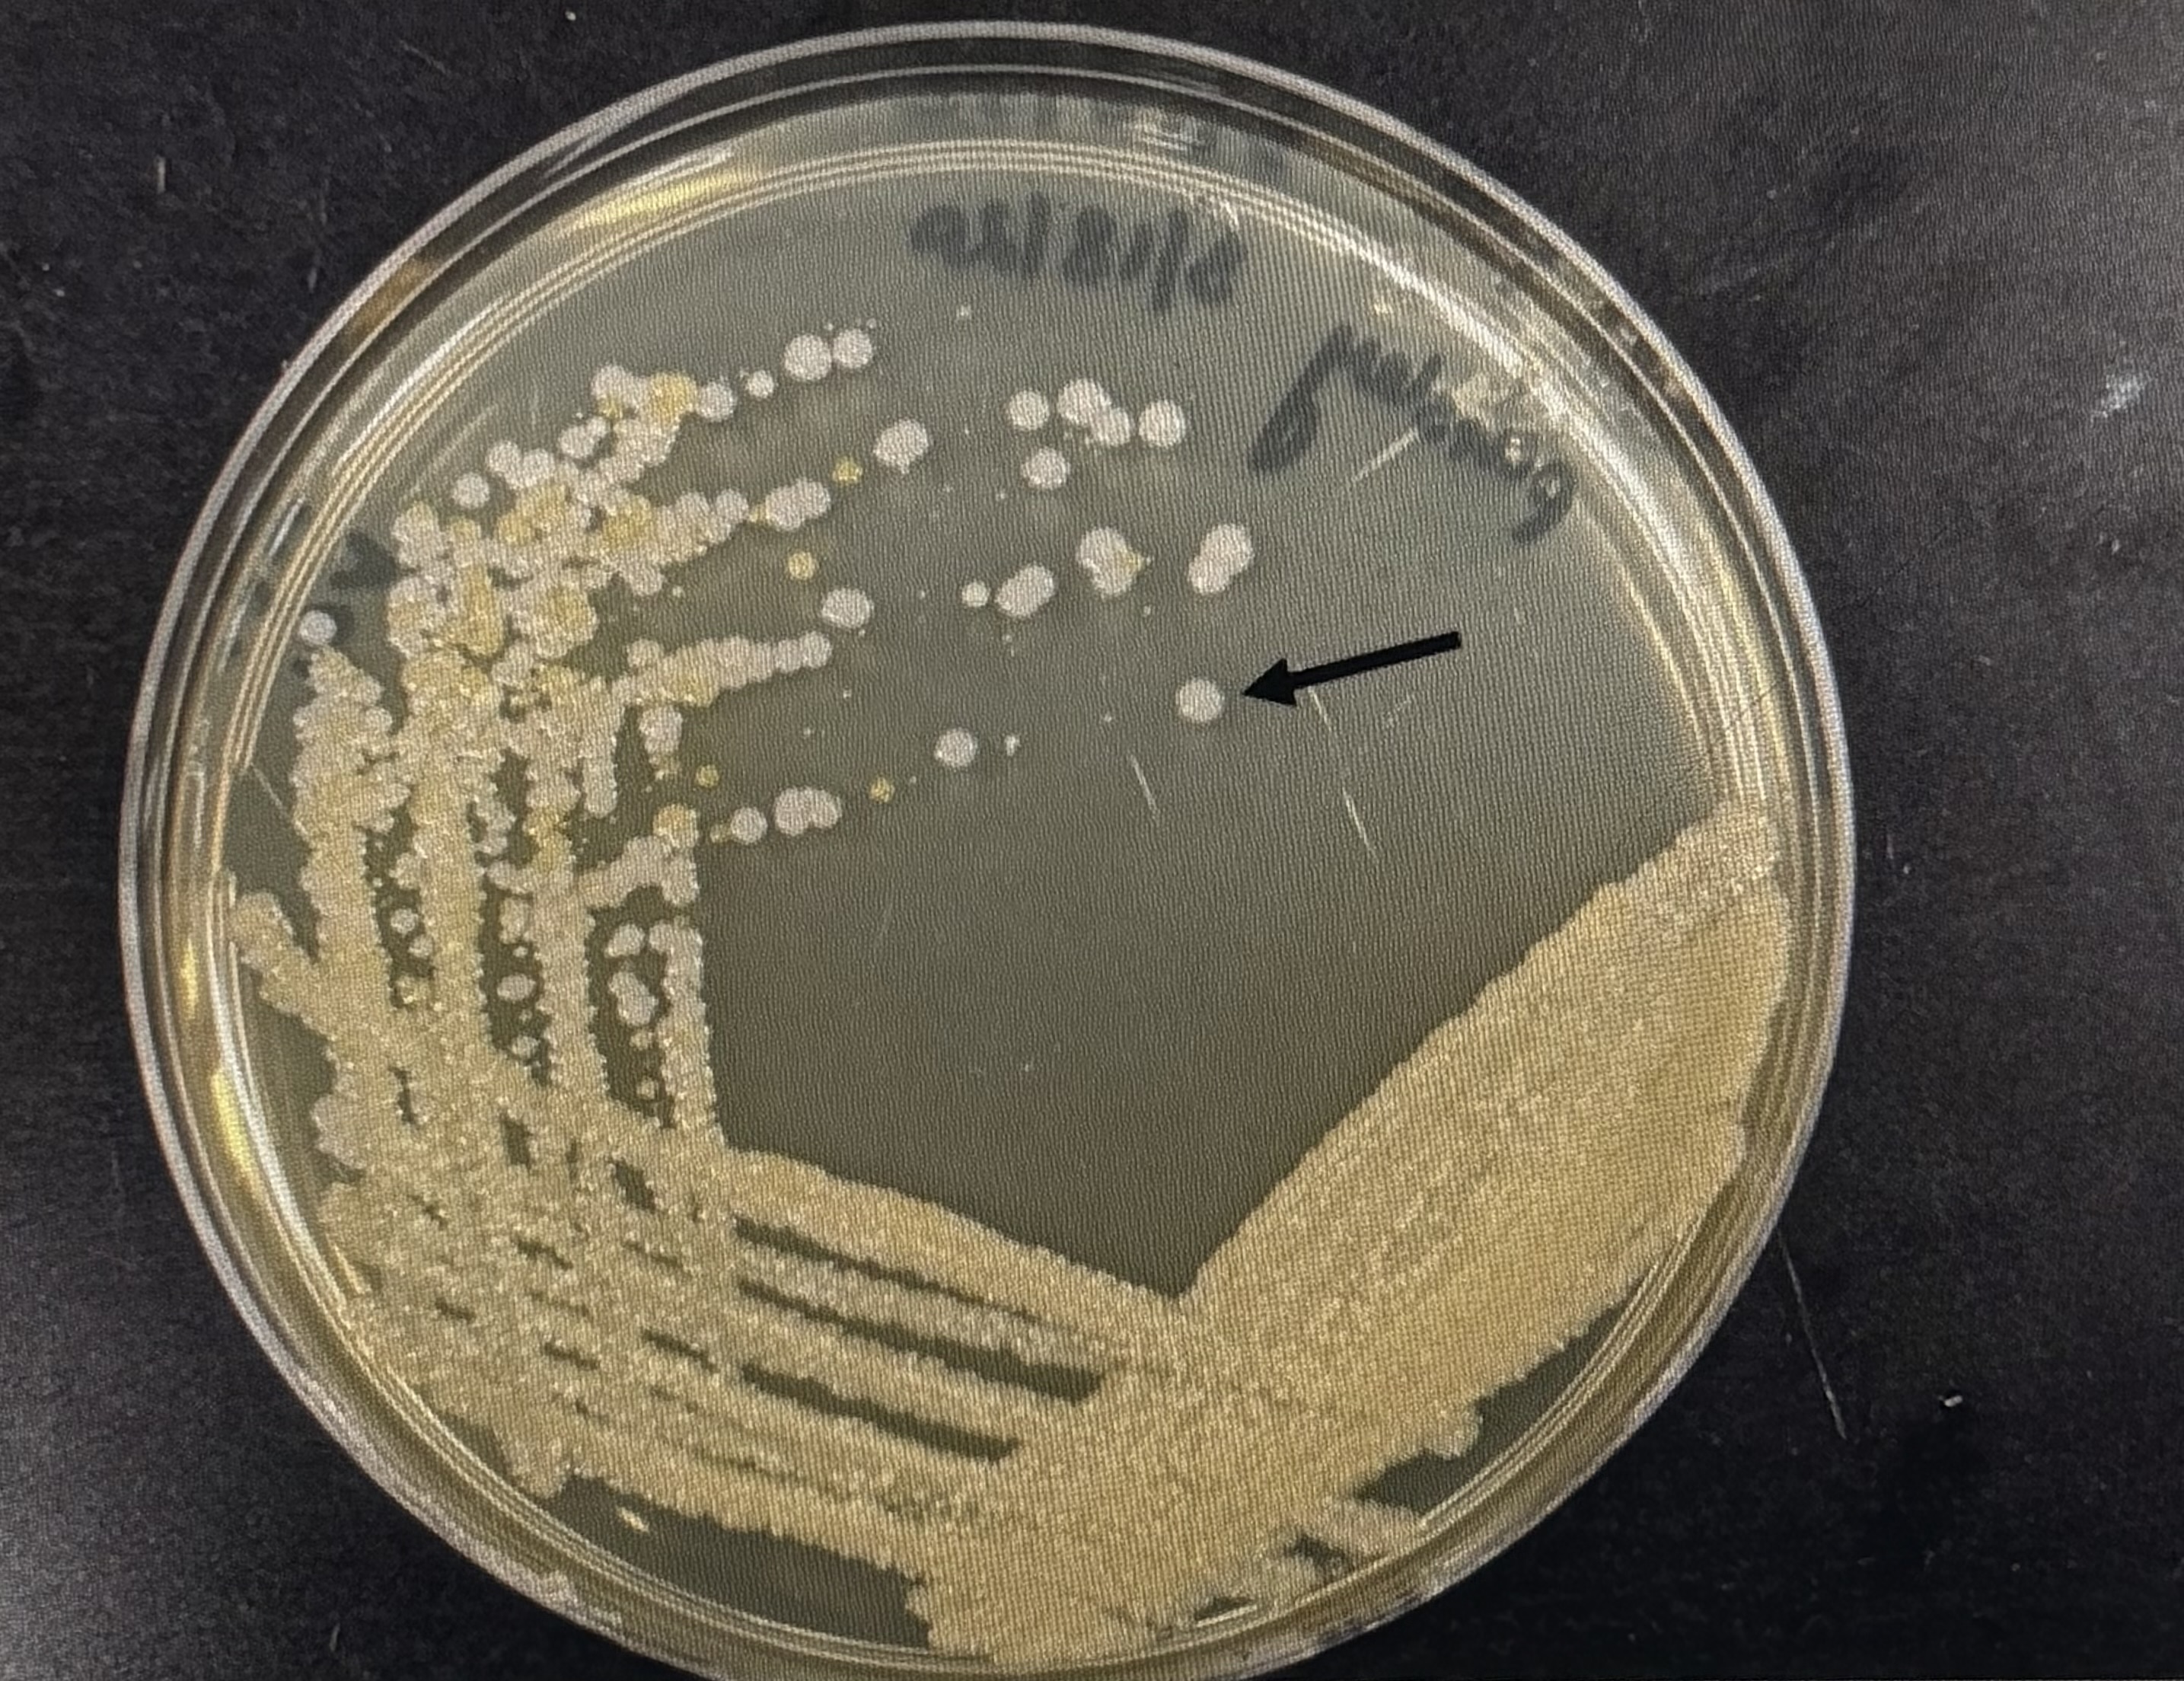
term image

1/70
Looks like no tags are added yet.
Name | Mastery | Learn | Test | Matching | Spaced | Call with Kai |
|---|
No study sessions yet.
While viewing a specimen under a microscope, a drop of oil must be used with which of the following lenses?
Group of answer choices
100X
10X
40X
4X
100x
While observing a specimen, you should always start with higher magnification and then switch to lower magnification.
Group of answer choices
True
False
false
Calculate the total magnification that will be obtained when you view a specimen under a microscope using 40X objective lens.
Group of answer choices
400X
40X
1000X
100X
40 × 10 (eye piece is 10x) = 400
Oil is used with the oil immersion objective to reduce loss of light due to refraction.
Group of answer choices
True
False
true
---------------- focuses the light from the bulb onto the specimen.
Group of answer choices
Condensor
Occular Lens
Objective Lens
Fine Adjustment Knob
condensor
1. List in steps, how you would transfer bacteria from a liquid culture to a plate. You have access to all the equipment discussed in the protocol for aseptic techniques.
1. Ensure proper PPE is on
2. Disinfect bench, wash hands, and put on new gloves
3. Light Bunsen burner
4. Light the loop until red and allow it to cool
5. Uncap the culture tube without setting the cap on the table
6. Put the tube opening on the flame
7. Put loop inside the tube to get bacteria
8. Put the tube top on the flame and recap
9. Take off the agar lid and use the loop to place bacteria onto the surface
10. Close the plate
11. Flame the loop again
You have accidentally spilled some bacterial culture on the lab floor. Name two reagents that you can use to clean the spill.
Bleach (10%) and or Ethanol (70%)
1. During an experiment, a beaker containing ethanol is accidentally set on fire. Describe how you will put out the ethanol fire.
Use an fire blanket or fire extinguisher—could also use lid to remove the oxygen.
While incubating plates for bacterial growth, the plates should be kept inverted. This is because
Group of answer choices
Plates are not stable if placed in an upright position
Oxygen will diffuse properly if plates are placed in an inverted position
plates will accumulate condensation on surface, if they are not inverted
It is easier to identify inverted plates because the labeled side faces up.
plates will accumulate condensation on surface, if they are not inverted
A bacterial colony represents
Group of answer choices
an empty petridish
progeny of a single cell
one single bacterial cell
a region on a plate where there is no growth
progeny of a single cell
The three domains of life include
Group of answer choices
Algae, Fungi and Protozoa
Viruses, Eukarya and Mitochondria
Viruses, Bacteria and Eukarya
Archaea, Bacteria and Eukarya
Archaea, Bacteria and Eukarya
Viruses are capable of independent growth while bacteria are not capable of independent growth on plates.
Group of answer choices
True
False
false
Viruses can form colonies on a nutrient agar plate.
Group of answer choices
True
False
false
Surface A supports the growth of bacteria
Surface A shows more growth of organisms than B
Surface B shows more growth of organisms than A
Surface A supports the growth of viruses
Surface A supports the growth of bacteria
Surface B shows more growth of organisms than A
A bacterial cell lacks a nucleus and other organelles.
Group of answer choices
True
False
true
Bacterial will continue to grow if nutrients in the bacterial environment are depleted.
Group of answer choices
True
False
false
Ubiquity of microbes refers to their ability to
Group of answer choices
metabolize different nutrients
assume different shapes
tolerate acidic conditions
grow everywhere
grows everywhere
The purpose of the streak plate method is to obtain isolated colonies on an agar plate.
Group of answer choices
True
False
true
While performing a quadrant streak, the purpose of sterilizing the loop between each quadrant is:
Group of answer choices
to reduce the number of bacteria in each quadrant
to prevent contamination of plate
to prevent contamination of the bacterial sample from which the plate was generated.
to make sure that bacteria will not be killed.
to reduce the number of bacteria in each quadrant
A bacterial colony is formed from a single bacterial cell
Group of answer choices
True
False
true

What was the purpose of picking samples from the quadrant 4?
individual, well isolated colonies in quadrant 4 will generate a pure culture
individual, well isolated colonies in quadrant 4 will generate a mixed culture
different bacteria are present in quadrants 4 and 1
quadrant 4 looks prettier than 1
individual, well isolated colonies in quadrant 4 will generate a pure culture
After performing a quadrant streak, you would expect to find isolated colonies in the --------quadrant
Group of answer choices
fourth quadrant
first quadrant
second quadrant
third quadrant
4th
The following plate was streaked in what order starting from first to last?
1,2,3,4
4,3,2,1
2,1,3,4
4,1,2,3
1,2,3,4
Which of the following statement(s) are correct about a bacterial colony?
Group of answer choices
Members are produced by repeated binary fissions
Members are genetically alike
Members are product of a single cell
All of the above are correct
All of the above are correct
bacterial colony

Which of the following conclusions can be definitely made about the sample used to streak the plate shown below? Select all of the correct answers for full credit.
The sample represents a mixed culture
The sample represents a pure culture
The sample contains bacteria
The sample contains viruses
The sample contains bacteria and is pure
Which of the following plates demonstrate Quadrant Streak method?
2
1
3
4
2
Colony morphology aids in identification of bacteria.
Group of answer choices
True
False
true
Based on the picture below, what can you definitely say about the original sample from which this plate was streaked?
The bacteria in the original sample are "heat loving"
The sample was obtained from soil
The sample contains different types of bacteria
The original sample contains ONLY bacteria.
The sample contains different types of bacteria
What definite conclusions can you make from the following picture? (FYI, all colonies shown in the picture are red in color).
The organisms shown here is a fungus
A pure culture is shown here.
The organism shown here was isolated from soil.
A mixed culture is shown here.
A pure culture is shown here.
Study of bacterial colony morphology gives the researcher information about shape of individual bacterial cells in the colony.
Group of answer choices
True
False
false
The colonies in the following picture can be described as:
Group of answer choices
circular, pigmented, mucoid, smooth
rhizoid, colorless, mucoid
filamentous, pigmented, dry
circular, lobate, mucoid, smooth
circular, pigmented, mucoid, smooth
The colonies shown in the picture have a ---------- margin.
Group of answer choices
undulate
erose
lobate
smooth
smooth
The texture of the colony shown in the picture is best described as
Group of answer choices
Mucoid
Circular
Dry
Rhizoid
mucoid
The colony shown in the picture has a ---------- margin.
Group of answer choices
smooth
punctiform
filamentous
lobate
lobate
Pigmentation (color) of the colony can aid in the identification of microorganisms.
Group of answer choices
True
False
true
Bacterial colonies can be described on the basis of:
1. Color and Opacity
2. Form and Margin
3. Elevation
4. Texture
5. Biochemical properties
1,2,3&5
1,2,3,4, & 5
4&5
1,2,3 & 4
1,2,3 & 4
The following image shows what type of cell?
Group of answer choices
Neither Gram negative nor Gram positive
Both Gram negative and Gram positive
Gram negative
Gram positive
gram negative
What can you conclude from the following picture of a gram stain?
Group of answer choices
Gram positive rods
Gram positive cocci
Gram negative, spiral shaped bacteria
Gram negative cocci
Gram negative, spiral shaped bacteria
Bacteria are differentiated into gram positive and gram negative cells based on differences in their ---------------.
Group of answer choices
Nucleus
Cytoplasm
Cell Wall
Ribosomes
cell wall
Which of the following describes the correct order of reagents used in Gram Stain technique?
Group of answer choices
Crystal Violet, Iodine, Safranin and Decolorizer
Crystal Violet, Iodine, Decolorizer and Safranin
Safranin, Iodine, Decolorizer and Crystal Violet
Decolorizer, Crystal Violet, Iodine and Safranin
Crystal Violet, Iodine, Decolorizer and Safranin
---------------- cells have a thin layer of peptidoglycan, while --------------- cells have a thick layer of peptidoglycan in their cell walls.
Group of answer choices
Gram negative, Gram negative
Gram positive, Gram positive
Gram negative, Gram positive
Gram postive, Gram negative
Gram negative, Gram positive
What conclusions can you draw about the following picture?
Group of answer choices
Cells are rod shaped, gram negative and arranged in a chain
Cells are rod shaped, gram positive and arranged in a chain.
Cells are rod shaped, gram negative, and arranged as single cells.
Cells are spherical shaped, gram positive and arranged in a chain
Cells are rod shaped, gram positive and arranged in a chain.
Which of the following statements is correct?
A. Gram negative cell has a thick peptidoglycan layer which can bind Crystal Violet.
B. Gram negative cells stain pink with Safranin because, in the previous step, the decolorizer disrupts the outer membrane, causing leakage of Crystal Violet stain.
C. Crystal Violet stains the outer membrane purple in Gram negative cells, because of which they cannot take up Safranin.
D. The function of Iodine during Gram staining is to dissolve the peptidoglycan layer.
Gram negative cells stain pink with Safranin because, in the previous step, the decolorizer disrupts the outer membrane, causing leakage of Crystal Violet stain. B
What can you definitively conclude about the picture below?
Group of answer choices
Pure culture is shown in the picture
All cells in the picture are rod shaped
Mixed culture is shown in the picture
All cells in the picture are gram postive
mixed culture
What can you conclude from the following picture of a gram stain?
Group of answer choices
Gram positive rods
Gram negative cocci
Mixed culture
Gram positive cocci
gram negative cocci
What can you conclude from the following picture of a gram stain?
Group of answer choices
Mixed culture is shown in the picture
Individual cells of gram negative bacteria
Gram positive bacteria growing in chains
Gram negative bacteria growing in chains
Gram positive bacteria growing in chains